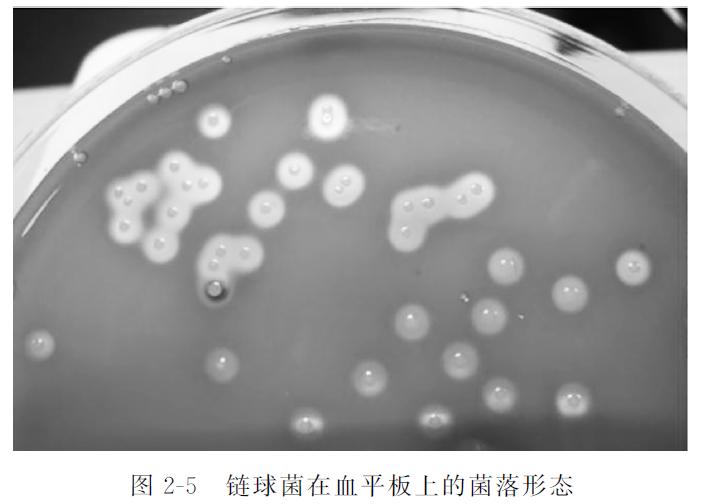
动物源性成分检测,动物源性农残检测

链球菌普遍存在于各种动物体内,大多数是宿主特异性的,不同的菌株感染不同种动物。链球菌可导致一系列的疾病,包括脑膜炎、败血症、多发性浆膜炎、关节炎、心内膜炎和肺炎。链球菌在鼻炎和流产的病例中也曾被分离到,说明它还和这两种病症有关。链球菌感染发病模式与严重程度因不同地区而异。链球菌有很多个血清型,其中猪链球菌至少有34个血清型。它们在致病性和临床症状方面各不相同,且同一血清型的致病性和临床症状在不同情况下也会有不同表现。有些血清型主要是从健康猪体内分离得到的,不具致病性;有的主要造成肺部损伤;有的可感染猪,也可感染其他动物。有的血清型,主要是2型,不仅可导致猪脑膜炎,偶尔还会造成人脑膜炎。
1 病原学特征
1.1 形态与染色
链球菌呈球形或卵圆形,直径0.6~1.0μm,呈链状排列,短者由4~8个细菌组成,长者由20~30个细菌组成,链的长短与细菌的种类和生长环境有关。在液体培养基中易呈长链,在固体培养基中常呈短链,由于链球菌能产生脱链酶,所以在正常情况下链球菌的链不能无限制地延长。多数菌株在血清肉汤中培养2~4h易形成透明质酸荚膜,继续培养后荚膜可被细菌自身产生的透明质酸酶分解而消失。该菌不形成芽孢,无鞭毛,易被普通的碱性染料着色,革兰氏染色(图2-4)阳性,长时间培养或被中性粒细胞吞噬后转为革兰氏染色阴性。

1.2 培养特征
需氧或兼性厌氧菌,对营养的要求较高,在普通培养基上生长不良,需补充血清、血液、葡萄糖等才能生长。最适生长温度为37℃,在20~42℃下能生长,最适pH为7.4~7.6。在血清肉汤中易呈长链,管底呈絮状或颗粒状沉淀生长。在血平板上形成灰白色、半透明、表面光滑、边缘整齐、直径0.5~0.75mm的细小菌落,不同菌株有不同溶血现象(图2-5)。
1.3 生化反应
分解葡萄糖,产酸不产气,对乳糖、甘露醇、水杨苷、山梨醇、棉子糖、海藻糖、七叶苷的分解能力因不同菌株而异。一般不分解菊糖,不被胆汁溶解,触酶试验阴性。
1.4 抗原结构
链球菌的抗原构造较复杂,主要有三种:
(1)核蛋白抗原 或称P抗原,无特异性,各种链球菌均相同,与葡萄球菌有交叉。
(2)多糖抗原 或称C抗原,为群特异性抗原,是细胞壁的多糖组分,可用稀盐酸等提取。应用多糖抗原,根据兰氏(Lancefield)血清学分类,可将链球菌分成许多群。目前有A、B、C、D、E、F、G、H、K、L、M、N、O、P、Q、R、S、T、U19个血清群,每个血清群又有若干个血清型。根据菌体荚膜抗原特性不同,猪链球菌共可分成35个血清型,即1~34型和同时含有1型和2型抗原的1/2型。
(3)蛋白质抗原 或称表面抗原,具有型特异性,位于多糖抗原外层,其中可分为M、T、R、S4种不同性质的抗原成分。与致病性有关的是M抗原,M抗原具有抗吞噬作用,并使链球菌易于黏附在上皮细胞上。根据M抗原不同可将A群链球菌分为60多个血清型。R、T、S抗原与致病性和毒力关系不大,但可用于链球菌的分型。
1.5 分类
根据链球菌在血液培养基上生长繁殖后是否溶血及其溶血性质,将其分为三类。
1.5.1 α-溶血性链球菌
菌落周围有1~2mm宽的草绿色溶血环,也称甲型溶血性链球菌,这类链球菌多为条件致病菌。
1.5.2 β-溶血性链球菌
菌落周围形成一个2~4mm宽、界限分明、完全透明的无色溶血环,也称乙型溶血性链球菌,这类菌亦称为溶血性链球菌,该菌的致病性强,常引起人类和动物的多种疾病。
1.5.3 γ-链球菌
不产生溶血素,菌落周围无溶血环,也称为丙型或不溶血性链球菌,该菌无致病性,常存在于乳类和粪便中,偶尔也引起人或动物感染。
1.6 抵抗力
该菌抵抗力一般不强,60℃经30min即被杀死,对常用消毒剂敏感,在干燥尘埃中可生存数月。乙型链球菌对青霉素、红霉素、氯霉素、四环素、磺胺均敏感。βG内酰胺类药物是链球菌感染的首选药物。
2 流行病学特征
链球菌在自然界中分布较广,存在于水、空气、尘埃、粪便及健康人和动物的口腔、鼻腔、咽喉中,可通过直接接触、空气飞沫传播感染或通过皮肤、黏膜伤口感染,被污染的食品如肉、蛋、乳及其制品也会感染人类。上呼吸道感染患者、人畜化脓性感染部位常成为食品污染的污染源。
3 危害
链球菌种类多,与人类有密切关系的是猪链球菌。在猪链球菌众多血清型中,2型链球菌是猪的最主要病原,致病性最强。链球菌的致病性与溶菌酶释放蛋白、胞外蛋白因子、溶血素等毒力因子有关。
在我国,2005年四川部分地区发生的2型猪链球菌病暴发流行导致200多人感染、38人死亡。在荷兰,每年屠宰场的工人和养殖场饲养员患猪链球菌脑膜炎的比率大约为3/100000,是不在屠宰场工作的人患猪链球菌脑膜炎的1500倍,屠夫患猪链球菌脑膜炎的比率为1.2/100000。在德国,屠夫、屠宰场工人和肉品加工厂工人是猪链球菌在鼻咽部定居的高危人群。在新西兰,1980年以后的研究显示9%的奶牛场主、10%的肉品检验员及21%的猪场主对猪链球菌2型血清反应为阳性,表明一些人有亚临床感染。
4 检测方法
包括病原的分离鉴定方法及分子生物学方法、免疫学方法ELISA等。
4.1 分离鉴定方法
4.1.1 样品处理
取25g(或25mL)待检样品,加入225mL灭菌生理盐水,制成混悬液。
4.1.2 接种培养
吸取5mL混悬液接种至50mL葡萄糖肉浸液肉汤中,或直接划线于血平板上(如待检样品污染严重,可同时接种5mL至匹克氏肉汤中),36℃培养24h,接种于血平板上,36℃培养24h,挑起乙型溶血圆形突起的细小菌落,在血平板上分纯,观察在液体和固体中的培养特征、溶血情况及革兰氏染色、形态,并进行环磷酸腺苷(CAMP)试验、链激酶试验和杆菌肽敏感试验。
4.1.3 CAMP试验
在血琼脂平板上用金黄色葡萄球菌培养物划一条直线,然后将链球菌培养物划一条线,与金黄色葡萄球菌培养物的划线相互垂直,但不要接触,二者相距3~5mm,各链球菌分离菌划线间距10~20mm。置37℃温箱内培养24h后观察结果。在两划线交界处出现箭头样的溶血区为阳性。
4.1.4 链激酶试验
吸取草酸钾血浆0.2mL,加0.8mL灭菌生理盐水,混匀,再加入链球菌18~24h36℃肉浸液肉汤培养物0.5mL及0.25%氯化钙0.25mL,混匀,36℃水浴10min,血浆混合物自行凝固,观察凝块重新完全溶解的时间,完全溶解为阳性,如24h后不溶解即为阴性。同时用肉浸液肉汤做阴性对照,用已知的链激酶阳性的菌株做阳性对照。
4.1.5 杆菌肽敏感试验
取典型菌落的菌液涂布于血平板上,用灭菌镊子夹取每片含有0.04U的杆菌肽纸片置于上述平板上,36℃培养18~24h,如有抑菌圈出现即为阳性。用已知的阳性菌株做对照。
4.2 分子生物学方法
挑取单个可疑菌落接种于Luria-Bertani(LB)肉汤培养基中,37℃振荡培养过夜,取1.0mL菌悬液于1.5mL离心管中,用冷冻离心机12000r/min离心10min,弃去上清液,再加入1.0mL灭菌双蒸水,涡旋制成菌悬液,放入水浴锅中煮沸10min,3000r/min离心5min,以上清液为模板进行扩增。上游引物为:5′-GTACAGTTGCTTCAGGACGTATC-3′,下游引物为:5′-ACGTTCGATTTCATCACGTT-3′。反应体系:10×buffer5μL,TaqDNA聚合酶(5U/μL)1μL,MgCl2溶液(25mmol/L)3μL,dNTP(2.5mmol/L)4μL,上游引物(10μmol/L)1μL,下游引物(10μmol/L)1μL,模板5μL,用ddH2O补至50μL。反应条件:95℃预变性5min,94℃变性1min,59℃退火1min,72℃延伸45s,共作用35个循环,72℃再延伸5min。PCR产物用1.5%的琼脂糖在100V条件下进行电泳,得到扩增长度为197bp的扩增产物为链球菌阳性。
4.3 ELISA
4.3.1 包被
用0.05mol/LpH9.0碳酸盐包被缓冲液,将抗体稀释至蛋白质含量为1~10μg/mL。在每个聚苯乙烯板的反应孔中加0.1mL抗体,4℃过夜。次日,弃去孔内溶液,用洗涤缓冲液洗3次,每次3min(以下简称洗涤)。
4.3.2 加样
加一定稀释的菌液0.1mL于上述已包被的反应孔中,置37℃孵育1h。然后洗涤(同时做空白孔,阴性对照孔及阳性对照孔)。
4.3.3 加酶标抗体
于各反应孔中加入新鲜稀释的酶标抗体(经滴定后的稀释度)0.1mL。37℃孵育0.5~1h,洗涤。
4.3.4 加底物液显色
于各反应孔中加入临时配制的TMB底物溶液0.1mL,37℃孵育10~30min。
4.3.5 终止反应
于各反应孔中加入2mol/L硫酸0.05mL。
4.3.6 结果判定
可于白色背景上,直接用肉眼观察结果:反应孔内颜色越深,阳性程度越强,阴性反应为无色或极浅,依据所呈颜色的深浅,以“+”“-”号表示。也可测OD值:在ELISA检测仪上,于450nm处,以空白对照孔调零后测各孔OD值,若大于规定的阴性对照OD值的2.1倍即为阳性。